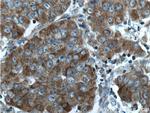
CNDP1 Antibody in Immunohistochemistry (Paraffin) (IHC (P))

Search
Proteintech
CNDP1 Polyclonal Antibody
{{$productOrderCtrl.translations['antibody.pdp.commerceCard.promotion.promotions']}}
{{$productOrderCtrl.translations['antibody.pdp.commerceCard.promotion.viewpromo']}}
{{$productOrderCtrl.translations['antibody.pdp.commerceCard.promotion.promocode']}}: {{promo.promoCode}} {{promo.promoTitle}} {{promo.promoDescription}}. {{$productOrderCtrl.translations['antibody.pdp.commerceCard.promotion.learnmore']}}
产品信息
17759-1-AP
种属反应
宿主/亚型
分类
类型
抗原
偶联物
形式
浓度
规格
纯化类型
保存液
内含物
保存条件
运输条件
产品详细信息
Immunogen sequence: YGRGATDNK GPVLAWINAV SAFRALEQDL PVNIKFIIEG MEEAGSVALE ELVEKEKDRF FSGVDYIVIS DNLWISQRKP AITYGTRGNS YFMVEVKCRD QDFHSGTFGG ILNEPMADLV ALLGSLVDSS GHILVPGIYD EVVPLTEEEI NTYKAIHLDL EEYRNSSRVE KFLFDTKEEI LMHLWRYPSL SIHGIEGAFD EPGTKTVIPG RVIGKFSIRL VPHMNVSAVE KQVTRHLEDV FSKRNSSNKM VVSMTLGLHP WIANIDDTQY LAAKRAIRTV FGTEPDMIRD GSTIPIAKMF QEIVHKSVVL IPLGAVDDGE HSQNEKINRW NYIEGTKLFA AFFLEMAQLH (160-508 aa encoded by BC110295)
靶标信息
This gene encodes a member of the M20 metalloprotease family. The encoded protein is specifically expressed in the brain, is a homodimeric dipeptidase which was identified as human carnosinase. This gene contains trinucleotide (CTG) repeat length polymorphism in the coding region.
仅用于科研。不用于诊断过程。未经明确授权不得转售。
生物信息学
蛋白别名: Beta-Ala-His dipeptidase; carnosinase 1; Carnosine dipeptidase 1; carnosine dipeptidase 1 (metallopeptidase M20 family); CNDP dipeptidase 1; Glutamate carboxypeptidase-like protein 2; Serum carnosinase; unnamed protein product
基因别名: AI746433; CN1; CNDP1; CPGL2; HsT2308; UNQ1915/PRO4380
UniProt ID: (Human) Q96KN2, (Mouse) Q8BUG2, (Rat) Q66HG3
Entrez Gene ID: (Human) 84735, (Mouse) 338403, (Rat) 307212